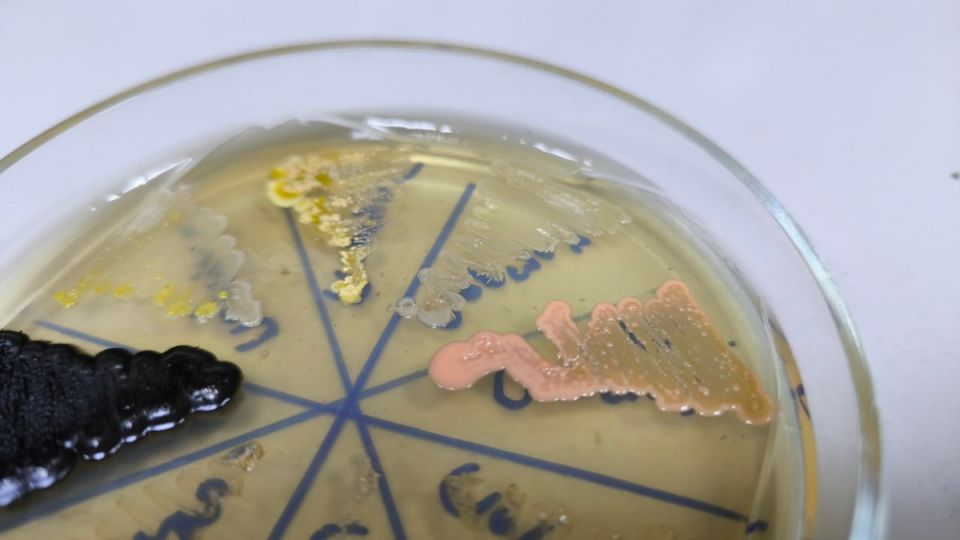
��������� ���: ������� � ������� ���������������

Микробы — это не просто незаметные обитатели нашего мира, они могут быть по-настоящему увлекательными и даже красивыми. Их взаимодействие поражает воображение. Например, представим себе картину, где желтый микроб, находящийся на позиции 11 часов, либо активизируется черным, либо подавляется желтым на позиции 12 часов. При этом желтый микроб на 12 часах, похоже, живет за счет своего соседа на 11, в то время как полупрозрачный на 13 часах создает напряжение в этой микросреде.
А что насчет розового микроба, который занимает позицию в 15 часов? Он ведет себя иначе: не подавляет никого и сам не оказывается под влиянием. Эта загадочная картинка прекрасно иллюстрирует, как многообразно и интересно может быть взаимодействие микроорганизмов в их микросреде.
Научное наблюдение
Интересно отметить, что при увеличении изображений этих культур можно видеть, что некоторые из них выглядят довольно запущенно. Это открытие подчеркивает, что в мире микробов есть еще много места для исследований и работы, в том числе и для будущих ученых, которые захотят разобраться в тонкостях микробиологии.
Будущее микробов
- Исследования продолжаются: Каждый новый день приносит открытия, которые могут изменить наше понимание микробов.
- Микробы и экосистема: Важно понимать, какую роль они играют в поддержании баланса в природе.
С этим знанием можно подойти к изучению микробов с новой точки зрения, открывая их тайны и возможности для будущего. Впереди множество загадок, которые жаждут быть разгаданными.